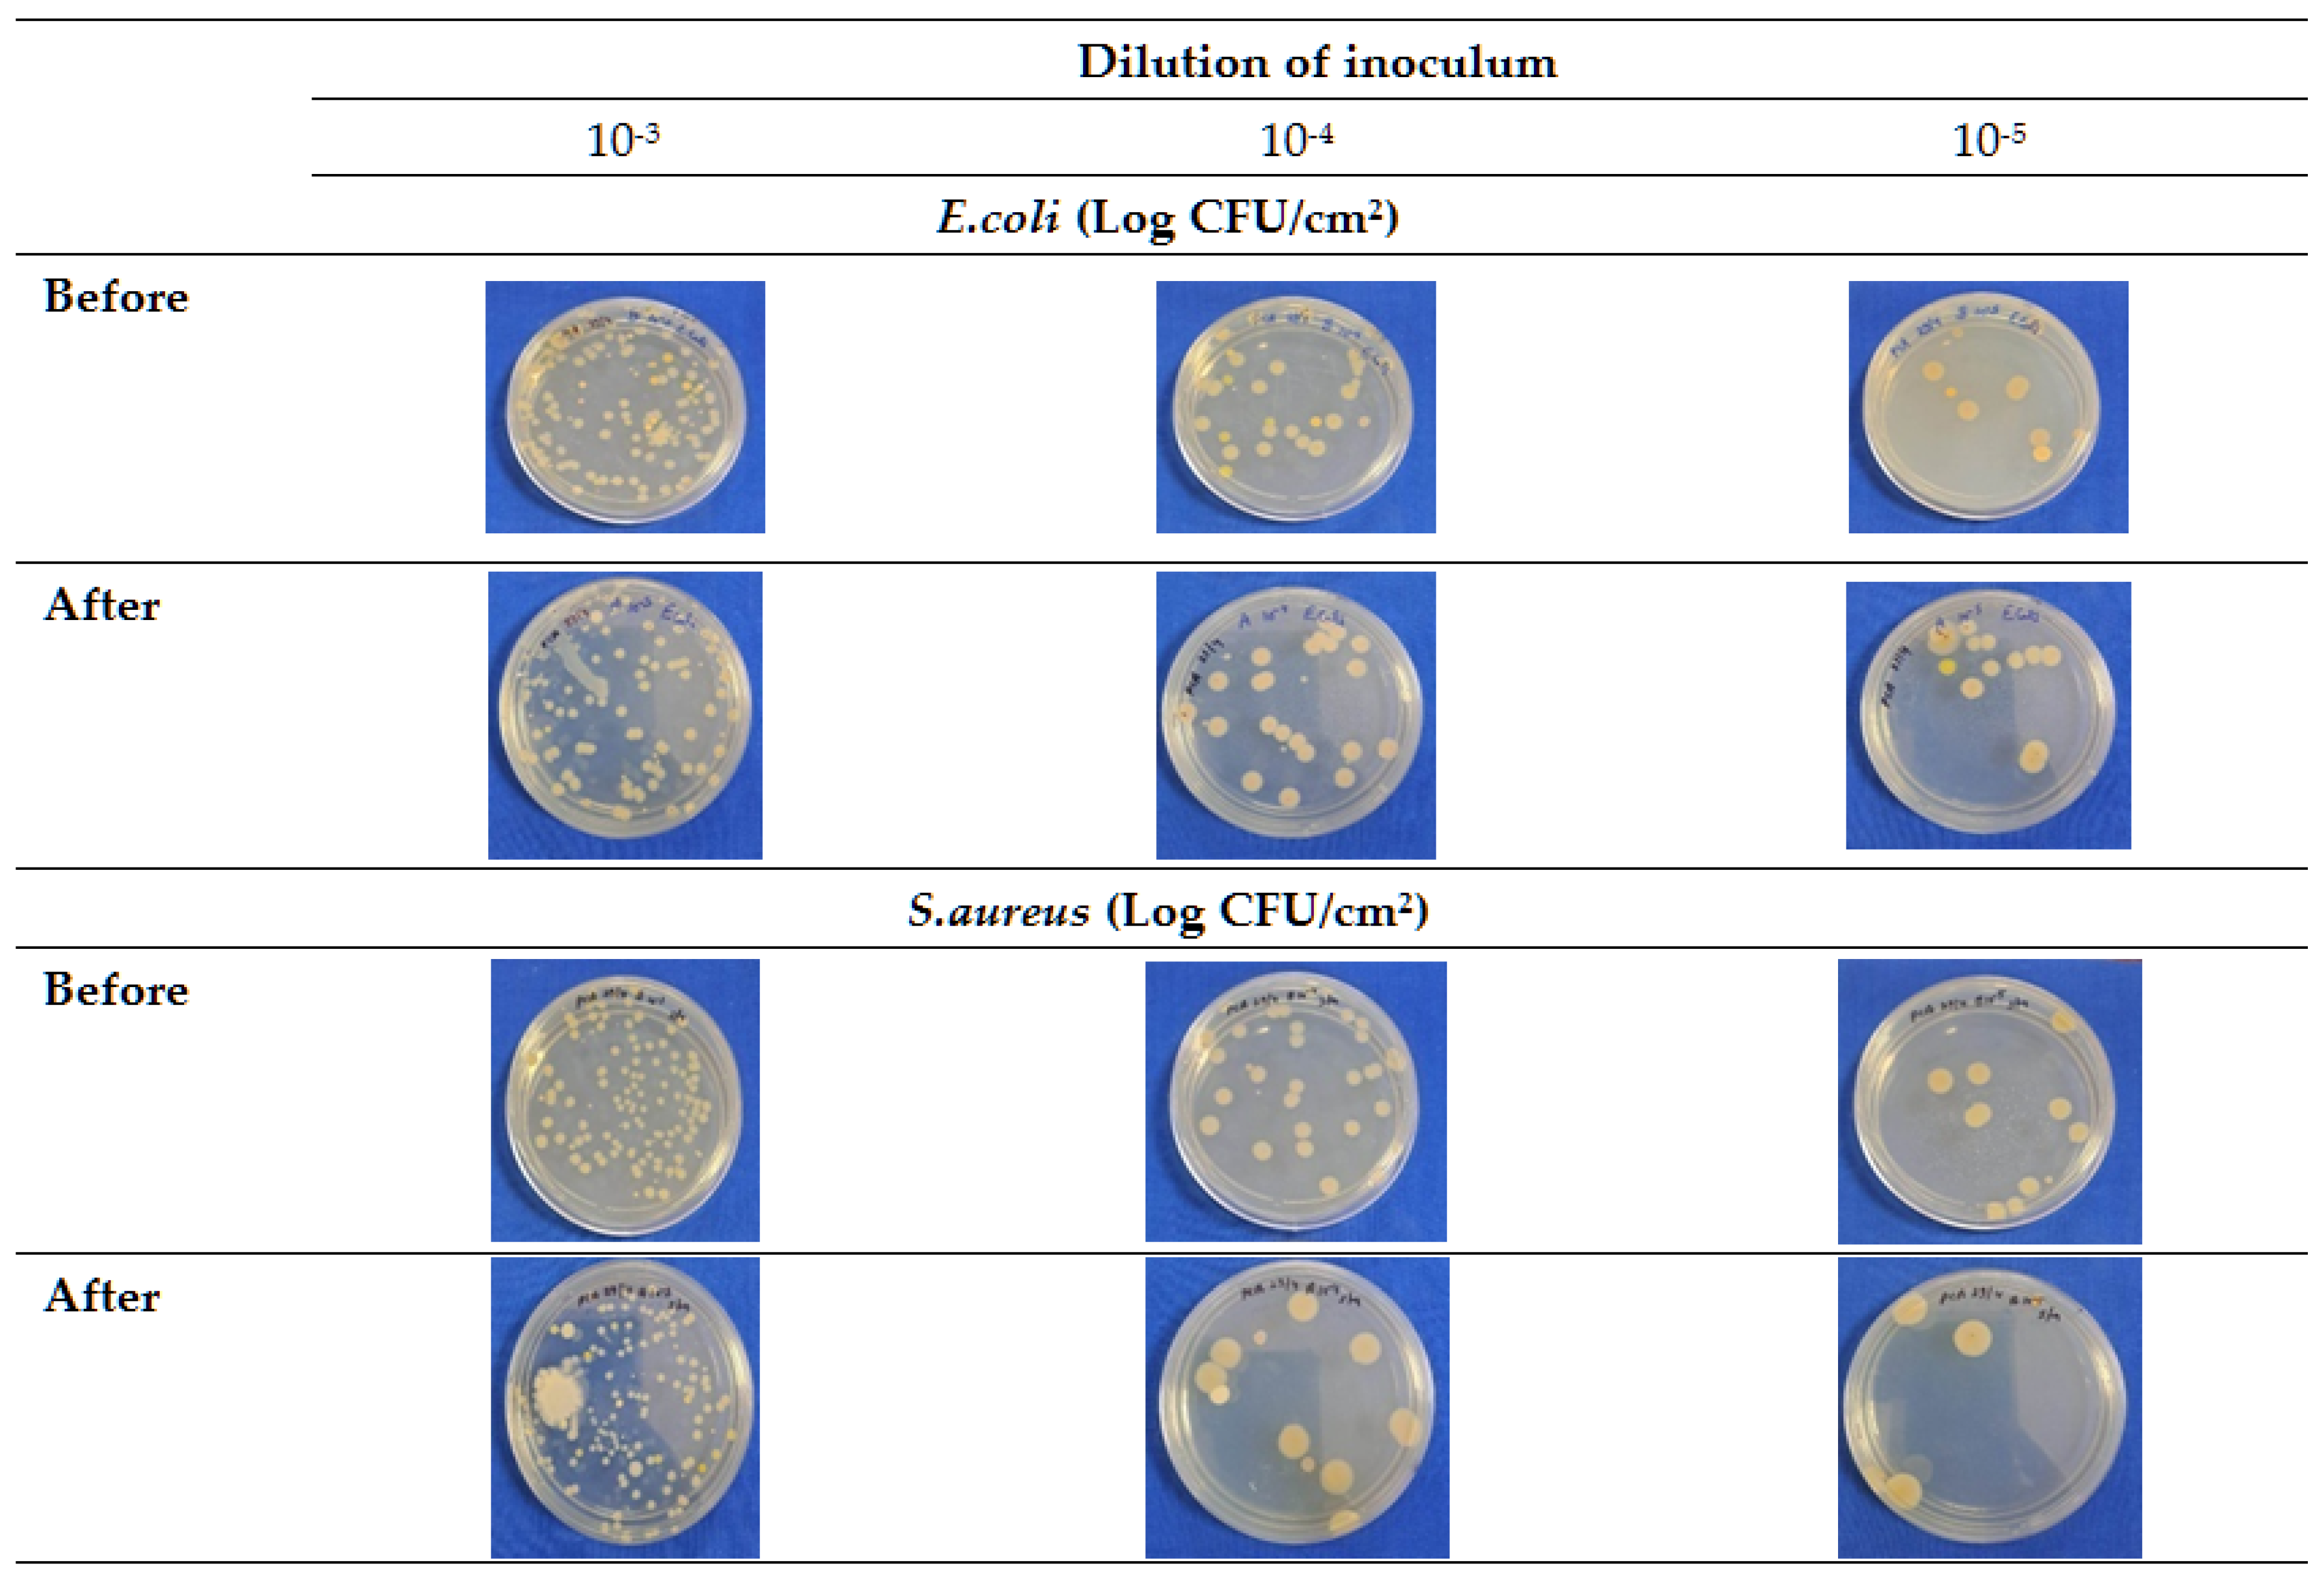
Foods 14 03391 g005 Foods 14 03391 g005
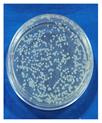
Foods 14 03391 i003 Foods 14 03391 i003
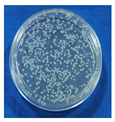
Foods 14 03391 i004 Foods 14 03391 i004
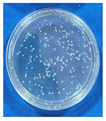
Foods 14 03391 i005 Foods 14 03391 i005
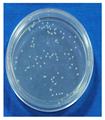
Foods 14 03391 i006 Foods 14 03391 i006

Enhancing Chicken Meat Quality with User-Friendly Decontamination Wipes
Abstract
1. Introduction
2. Materials and Methods
2.1. Selection of Ingredients and Formulation of Decontamination Solution
2.2. Estimation of Antimicrobial Compounds in Crude Plant Extracts
2.3. Selection of Base Material for Preparing Decontamination Wipes
2.4. Evaluation of Microbial Quality of Market Chicken Samples and Comparative Antimicrobial Effect of Developed Wipe Against Traditional Decontaminants
2.5. Evaluation of the Effects of the DW on the Quality Attributes of Chicken Meat Samples
2.5.1. Evaluation of Quality Parameters of Stored Chicken Meat
pH
Extract Release Volume
Total Volatile Basic Nitrogen
Microbiological Parameters
Sensory Parameters
2.6. Statistical Analysis
3. Results and Discussion
3.1. Antimicrobial Efficacy of the Selected Ingredients for Decontamination Solution
3.2. Formulation of DS and Evaluation of Its Antimicrobial Efficacy
3.3. Base Material for Decontamination Wipes (DWs)
3.4. Assessment of the Microbial Quality of Market Chicken Meat Sample
3.5. Decontamination Effects of Developed DW
3.6. Effect of Wipe Treatment on Quality Parameters of Chicken Meat During Storage at 4 ± 1 °C
3.6.1. Changes in Physicochemical Quality Parameters
3.6.2. Changes in Microbial Quality Parameters
Evaluation of Antimicrobial Efficacy of DW by Spiking Test
3.6.3. Sensory Quality Parameters
4. Conclusions
Supplementary Materials
Author Contributions
Funding
Informed Consent Statement
Data Availability Statement
Acknowledgments
Conflicts of Interest
References
- Chen, P.J.; Antonelli, M. Conceptual models of food choice: Influential factors related to foods, individual differences, and society. Foods 2020, 9, 1898. [Google Scholar] [CrossRef]
- Hayat, M.N.; Ismail-Fitry, M.R.; Kaka, U.; Rukayadi, Y.; Ab Kadir, M.Z.A.; Radzi, M.A.M.; Kumar, P.; Nurulmahbub, N.A.; Sazili, A.Q. Assessing meat quality and textural properties of broiler chickens: The impact of voltage and frequency in reversible electrical water-bath stunning. Poult. Sci. 2024, 103, 103764. [Google Scholar] [CrossRef]
- VapaTankosić, J.; Hanić, H.; Bugarčić, M. Consumer’s characteristics and attitudes towards organic food products in times of COVID-19 pandemic. Econ. Agric. 2022, 69, 469–481. [Google Scholar]
- Hertanto, B.S.; Nurmalasari, C.D.A.; Nuhriawangsa, A.M.P.; Cahyadi, M.; Kartikasari, L.R. The physical and microbiological quality of chicken meat in the different type of enterprise poultry slaughterhouse: A case study in Karanganyar District. IOP Conf. Ser. Earth Environ. Sci. 2018, 102, 012051. [Google Scholar] [CrossRef]
- Boziaris, I.S.; Kordila, A.; Neofitou, C. Microbial spoilage analysis and its effect on chemical changes and shelf-life of Norway lobster (Nephrops norvegicus) stored in air at various temperatures. Int. J. Food Sci. Technol. 2011, 46, 887–895. [Google Scholar] [CrossRef]
- Gonçalves-Tenório, A.; Silva, B.N.; Rodrigues, V.; Cadavez, V.; Gonzales-Barron, U. Prevalence of pathogens in poultry meat: A meta-analysis of European published surveys. Foods 2018, 7, 69. [Google Scholar] [CrossRef]
- Greeshma, S.M.; Rajeev, T.S.; Jiji, R.S.; Sathu, T.; Mohan, S.K. Knowledge of chicken retail entrepreneurs on hygienic slaughtering practices in municipal areas of Kerala. J. Vet. Anim. Sci. 2023, 55, 338–345. [Google Scholar] [CrossRef]
- Islam, R.; Islam, S.; Rahman, M. Assessment of hygienic and sanitation practices among poultry butchers in selected municipality areas of Assam (India). J. Vet. Anim. Sci. 2022, 53, 269–278. [Google Scholar] [CrossRef]
- Koolman, L.; Whyte, P.; Meade, J.; Lyng, J.; Bolton, D. Use of chemical treatments applied alone and in combination to reduce Campylobacter on raw poultry. Food Control 2014, 46, 299–303. [Google Scholar] [CrossRef]
- Paulsen, P.; Csadek, I.; Bauer, A.; Bak, K.H.; Weidinger, P.; Schwaiger, K.; Nowotny, N.; Walsh, J.; Martines, E.; Smulders, F.J.M. Treatment of fresh meat, fish and products thereof with cold atmospheric plasma to inactivate microbial pathogens and extend shelf life. Foods 2022, 11, 3865. [Google Scholar] [CrossRef]
- Eccoña Sota, A.; Cap, M.; Rodriguez, A.; Szerman, N.; Speroni, F.; Vaudagna, S.R. Effects of high hydrostatic pressure and beef patty formulations on the inactivation of native strains of Shiga toxin-producing Escherichia coli O157:H7. Food Bioproc. Technol. 2021, 14, 1194–1198. [Google Scholar] [CrossRef]
- Incili, G.K.; Akgöl, M.; Karatepe, P.; Tekin, A.; Kanmaz, H.; Kaya, B.; Hayaloğlu, A.A. Whole-cell postbiotics: An innovative approach for extending the shelf life and controlling major foodborne pathogens in chicken breast fillets. Food Bioproc. Technol. 2023, 16, 1502–1524. [Google Scholar] [CrossRef]
- Meredith, H.; Walsh, D.; McDowell, D.A.; Bolton, D.J. An investigation of the immediate and storage effects of chemical treatments on Campylobacter and sensory characteristics of poultry meat. Int. J. Food Microbiol. 2013, 166, 309–315. [Google Scholar] [CrossRef]
- Bolton, D.J.; Meredith, H.; Walsh, D.; McDowell, D.A. The effect of chemical treatments in laboratory and broiler plant studies on the microbial status and the shelf-life of poultry. Food Control 2014, 36, 230–237. [Google Scholar] [CrossRef]
- Malheiro, J.F.; Oliveira, C.; Cagide, F.; Borges, F.; Simões, M.; Maillard, J.Y. Surface wiping test to study biocide-cinnamaldehyde combination to improve efficiency in surface disinfection. Int. J. Mol. Sci. 2020, 21, 7852. [Google Scholar] [CrossRef]
- Malheiro, J.F.; Maillard, J.Y.; Borges, F.; Simões, M. Biocide potentiation using cinnamic phytochemicals and derivatives. Molecules 2019, 24, 3918. [Google Scholar] [CrossRef]
- Elfadil, A.G.; Karamallah, A.A.; Abualhassan, A.M.; Hamid, A.A.; Sabahelkhier, M.K. Antimicrobial activities of Syzygium cumini leaf extracts against selected microorganisms. Nova J. Med. Biol. Sci. 2015, 4, 1–8. [Google Scholar] [CrossRef]
- Fernandes, P.A.d.S.; Pereira, R.L.S.; Santos, A.T.L.d.; Coutinho, H.D.M.; Morais-Braga, M.F.B.; da Silva, V.B.; Costa, A.R.; Generino, M.E.M.; de Oliveira, M.G.; de Menezes, S.A.; et al. Phytochemical analysis, antibacterial activity and modulating effect of essential oil from Syzygium cumini (L.) skeels. Molecules 2022, 27, 3281. [Google Scholar] [CrossRef]
- Silva, C.C.A.R.; Gomes, C.L.; Danda, L.J.A.; Roberto, A.E.M.; de Carvalho, A.M.R.; Ximenes, E.C.P.A.; da Silva, R.M.F.; Angelos, M.A.; Rolim, L.A.; Neto, P.J.R. Optimized microwave-assisted extraction of polyphenols and tannins from Syzygium cumini (L.) Skeels leaves through an experimental design coupled to a desirability approach. An. Acad. Bras. Cienc. 2021, 93, e20190632. [Google Scholar] [CrossRef]
- Khan, S.; Imran, M.; Imran, M.; Pindari, N. Antimicrobial activity of various ethanolic plant extracts against pathogenic multi drug resistant Candida spp. Bioinformation 2017, 13, 67–72. [Google Scholar] [CrossRef]
- Swami, S.B.; Thakor, N.S.J.; Patil, M.M.; Haldankar, P.M. Jamun (Syzygium cumini L.): A review of its food and medicinal uses. Food Nutr. Sci. 2012, 3, 1100–1117. [Google Scholar] [CrossRef]
- Jagetia, G.C. Bioactive phytoconstituents and medicinal properties of Jamun (Syzygium cumini). J. Explor. Res. Pharmacol. 2024, 9, 180–212. [Google Scholar] [CrossRef]
- Posgay, M.; Greff, B.; Kapcs, V.; Lakatos, E. Effect of Thymus vulgaris L. essential oil and thymol on the microbiological properties of meat and meat products: A review. Heliyon 2022, 8, e10812. [Google Scholar] [CrossRef]
- Mani-López, E.; García, H.S.; López-Malo, A. Organic acids as antimicrobials to control Salmonella in meat and poultry products. Food Res. Int. 2012, 45, 713–721. [Google Scholar] [CrossRef]
- Hoang, Y.T.H.; Vu, A.T.L. Sodium benzoate and potassium sorbate in processed meat products collected in Ho Chi Minh City, Vietnam. Int. J. Adv. Sci. Eng. Inf. Technol. 2016, 6, 477–482. [Google Scholar] [CrossRef]
- de Souza de Azevedo, P.O.; Converti, A.; Gierus, M.; de Souza Oliveira, R.P. Application of nisin as biopreservative of pork meat by dipping and spraying methods. Braz. J. Microbiol. 2019, 50, 523–526. [Google Scholar] [CrossRef]
- Rengasamy, R.S. Composite nonwovens in wipes. In Composite Non-Woven Materials; Das, D., Pourdeyhimi, B., Eds.; Woodhead Publishing: Cambridge, UK, 2014; pp. 89–119. [Google Scholar]
- Saad, S.M.; Khaterb, D.F.; Zaki, S.M. Food poisoning bacteria in ready-to-eat meat and chicken meat products. Benha Vet. Med. J. 2018, 35, 301–310. [Google Scholar] [CrossRef]
- Abdelrahman, H.A.; Ismail, T.H.; Saleh, N.G.E.; Ahmed, N.I.H. Bacteriological profile and safety of chicken broiler meat cuts. J. Adv. Vet. Res. 2022, 12, 399–403. [Google Scholar]
- Doaa, A.M.; Edris, A.M.; Nasseif, M.Z.; Elrais, A.M. Prevalence of Escherichia coli and Staphylococcus aureus in meat and chicken meat meals served at governmental hospital. Benha Vet. Med. J. 2020, 39, 55–58. [Google Scholar]
- Biswas, A.K.; Chatli, M.K.; Sahoo, J. Antioxidant potential of curry (Murrayakoenigii L.) and mint (Mentha spicata) leaf extracts and their effect on colour and oxidative stability of raw ground pork meat during refrigeration storage. Food Chem. 2012, 133, 467–472. [Google Scholar] [CrossRef] [PubMed]
- Mathi, P.; Banu Priya, J. Analysis of natural almond and jamun leaves combined extraction for enhancement of antibacterial functionality. Int. J. Creat. Res. Thoughts 2021, 9, a411–a415. [Google Scholar]
- Valgas, C.; Souza, S.M.D.; Smania, E.F.; Smania, A., Jr. Screening methods to determine antibacterial activity of natural products. Braz. J. Microbiol. 2007, 38, 369–380. [Google Scholar] [CrossRef]
- Balouiri, M.; Sadiki, M.; Ibnsouda, S.K. Methods for in vitro evaluating antimicrobial activity: A review. J. Pharm. Anal. 2016, 6, 71–79. [Google Scholar] [CrossRef]
- Abdel-Aziz, N.M.; Hassanien, A.A. The impact of clove and thyme essential oils on Listeria monocytogenes isolated from meat and poultry products. SVU Int. J. Vet. Sci. 2022, 5, 104–111. [Google Scholar] [CrossRef]
- Theron, M.M.; Lues, J.F.R. Organic acids and meat preservation: A review. Food Rev. Int. 2007, 23, 141–158. [Google Scholar] [CrossRef]
- Yu, H.H.; Chin, Y.W.; Paik, H.D. Application of natural preservatives for meat and meat products against food-borne pathogens and spoilage bacteria: A review. Foods 2021, 10, 2418. [Google Scholar] [CrossRef]
- Mahmoud, I.I.; Marzouk, M.S.A.; Moharram, F.A.; El-Gindi, M.R.; Hassan, A.M.K. Acylated flavonol glycosides from Eugenia jambolana leaves. Phytochemistry 2001, 58, 1239–1244. [Google Scholar] [CrossRef]
- de Oliveira, G.F.; Furtado, N.A.J.C.; da Silva-Filho, A.A.; Martins, C.H.G.; Bastos, J.K.; Cunha, W.R. Antimicrobial activity of Syzygiumcumini (Myrtaceae) leaves extract. Braz. J. Microbiol. 2007, 38, 381–384. [Google Scholar] [CrossRef]
- Amorim, E.L.C.; Nascimento, J.E.; Monteiro, J.M.; Sobrinho, T.J.S.P.; Araujo, T.A.S.; Albuquerque, U.P. A simple and accurate procedure for the determination of tannin and flavonoid levels and some applications in ethnobotany and ethnopharmacology. Funct. Ecosyst. Communities 2008, 2, 88–94. [Google Scholar]
- Trout, E.S.; Hunt, M.C.; Johnson, D.E.; Claus, J.R.; Kastner, C.L.; Kropt, D.H. Characteristics of low-fat ground beef containing texture-modifying ingredients. J. Food Sci. 1992, 57, 19–24. [Google Scholar] [CrossRef]
- Strange, E.D.; Benedict, R.C.; Smith, J.L.; Swift, C.E. Evaluation of rapid test for monitoring alteration in meat quality during storage. J. Food Prot. 1977, 40, 843–847. [Google Scholar] [CrossRef] [PubMed]
- Pearson, D. Methods related to protein breakdown. J. Sci. Food Agric. 1968, 19, 366–369. [Google Scholar] [CrossRef]
- Atlabachew, T.; Mamo, J. Microbiological quality of meat and swabs from contact surface in butcher shops in Debre Berhan, Ethiopia. J. Food Qual. 2021, 2021, 7520882. [Google Scholar] [CrossRef]
- APHA. Compendium of Method for Microbiological Examination of Food, 4th ed.; Speck, M.L., Ed.; American Public Health Association: Washington, DC, USA, 2001. [Google Scholar]
- ICMSF. Microorganisms in Foods 7. Microbiological Testing in Food Safety Management; Kluwer Academic/Plenum Publishers: New York, NY, USA, 2002. [Google Scholar]
- Cross, H.P.; Bernholdt, H.F.; Dikeman, M.E.; Greene, B.E.; Moody, W.G.; Staggs, R.; West, R.L. Guidelines for Cookery and Sensory Evaluation of Meat; American Meat Science Association: Chicago, IL, USA, 1978. [Google Scholar]
- Talukder, S.; Mendiratta, S.K.; Biswas, A.K.; Kandeepan, G.; Kumar, R.R.; Aggrawal, R.K.; Soni, A.; Kumar, D.; Ahamad, T.; Devadason, I.P.; et al. Monitoring of chicken meat quality by plant dye based sensor. Food Bioproc. Technol. 2023, 16, 2217–2230. [Google Scholar] [CrossRef]
- Meilgaard, M.; Civille, G.V.; Carr, B.T. Sensory Evaluation Techniques, 4th ed.; CRC Press: Boca Raton, FL, USA, 2007. [Google Scholar]
- Duncan, D.B. Multiple range and multiple F test. Biometrics 1995, 1, 1–8. [Google Scholar] [CrossRef]
- Mystkowska, J.; Dąbrowski, J.R.; Kowal, K.; Niemirowicz, K.; Car, H. Physical and chemical properties of deionized water and saline treated with low-pressure and low-temperature plasma. Chemik 2013, 67, 722–724. [Google Scholar]
- Shafi, P.M.; Rosamma, M.K.; Jamil, K.; Reddy, P.S. Antibacterial activity of Syzygium cumini and Syzygiumtravancoricum leaf essential oils. Fitoterapia 2002, 73, 414–416. [Google Scholar] [CrossRef]
- Indriaty, I.; Ginting, B.; Hasballah, K.; Djufri, D. A Comparative study of total tannin contents and antimicrobial activities in methanol extracts of Rhizophoraceae Species. Heca J. Appl. Sci. 2023, 1, 62–70. [Google Scholar] [CrossRef]
- Pushpahasni, K.; Sharmila, R.S.; Dhasarathan, P. Efficiency of in-vitro antibacterial activity of Syzygium cumini phenolic extract from leaves. Asian J. Pharm. Clin. Res. 2015, 8, 211–214. [Google Scholar]
- Sousa, L.D.S.; Cabral, B.V.; Madrona, G.S.; Cardoso, V.L.; Miranda Reis, M.H. Purification of polyphenols from green tea leaves by ultrasound assisted ultrafiltration process. Sep. Purif. Technol. 2016, 168, 188–198. [Google Scholar] [CrossRef]
- Balyan, U.; Verma, S.P.; Sarkar, B. Phenolic compounds from Syzygium cumini (L.) Skeels leaves: Extraction and membrane purification. J. Appl. Res. Med. Aromat. Plants 2019, 12, 43–58. [Google Scholar] [CrossRef]
- Scrinivasan, D.; Nathan, S.; Suresh, T.; Perumalsamy, O. Antimicrobial activity of certain Indian medicinal plants used in folkloric medicine. J. Ethnopharmacol. 2001, 74, 217–220. [Google Scholar] [CrossRef]
- Zgurskaya, H.I.; Rybenkov, V.V. Permeability barriers of Gram-negative pathogens. Ann. N. Y. Acad. Sci. 2020, 1459, 5–18. [Google Scholar] [CrossRef] [PubMed]
- Park, K.M.; Kim, H.J.; Choi, J.Y.; Koo, M. Antimicrobial effect of acetic acid, sodium hypochlorite, and thermal treatments against psychrotolerant Bacillus cereus group isolated from lettuce (Lactuca sativa L.). Foods 2021, 10, 2165. [Google Scholar] [CrossRef]
- Sofos, J.N. Antimicrobial effects of sodium and other ions in foods: A review. J. Food Saf. 1983, 6, 45–78. [Google Scholar] [CrossRef]
- Al-Khikani, F.H.O.; Nima, A.R.; Salah, A.M.; Hadi, B.I.; Badran, B.H.; Ghazi, B.K.; Darwesh, T.F.; Abd Alabaas, H.M.; Tourki, T.A.; Noor, T.H. Activity of sodium bicarbonate against Escherichia coli. Med. Sci. J. Sci. Res. 2023, 4, 183–188. [Google Scholar]
- Chen, H.; Zhong, O. Antibacterial activity of acidified sodium benzoate against Escherichia coli O157:H7, Salmonella enterica, and Listeria monocytogenes in tryptic soy broth and on cherry tomatoes. Int. J. Food Microbiol. 2018, 274, 38–44. [Google Scholar] [CrossRef]
- Corral, L.G.; Post, L.; Montville, T.J. Antimicrobial activity of sodium bicarbonate. J. Food Sci. 2006, 53, 981–982. [Google Scholar] [CrossRef]
- Stanojevic, D.; Comic, L.; Stefanovic, O.; Solujic-Sukdolak, S.L. Antimicrobial effects of sodium benzoate, sodium nitrite and potassium sorbate and their synergistic action in vitro. Bulg. J. Agric. Sci. 2009, 15, 307–311. [Google Scholar]
- Sofos, J.N.; Pierson, M.D.; Blocher, J.C.; Busta, F.F. Mode of action of sorbic acid on bacterial cells and spores. Int. J. Food Microbiol. 1986, 3, 1–17. [Google Scholar] [CrossRef]
- Khwaza, V.; Aderibigbe, B.A. Antibacterial activity of selected essential oil components and their derivatives: A review. Antibiotics 2025, 14, 68. [Google Scholar] [CrossRef]
- Burt, S. Essential oils: Their antibacterial properties and potential applications in foods—A review. Int. J. Food Microbiol. 2004, 94, 223–253. [Google Scholar] [CrossRef]
- Anzlovar, S.; Baricevic, D.; Avguštin, J.A.; Koce, J.D. Essential oil of common thyme as a natural antimicrobial food additive. Food Technol. Biotechnol. 2014, 52, 263–268. [Google Scholar]
- Hansen, J.N. Nisin as a model food preservative. Crit. Rev. Food Sci. Nutr. 1994, 34, 69–93. [Google Scholar] [CrossRef] [PubMed]
- Li, Q.; Montalban-Lopez, M.; Kuipers, O.P. Increasing the antimicrobial activity of nisin-based lantibiotics against Gram-negative pathogens. Appl. Environ. Microbiol. 2018, 84, e00052-18. [Google Scholar] [CrossRef]
- El-Dessouki, H.A. Study of Some non-woven hygiene products properties manufactured in Egypt. J. Am. Sci. 2013, 9, 423–425. [Google Scholar]
- Das, D.; Pradhan, A.K.; Behnam, P. Dependence of the liquid absorption behavior of nonwovens on their material and structural characteristics: Modeling and experiments. J. Appl. Polym. Sci. 2012, 126, 1053–1060. [Google Scholar] [CrossRef]
- Masuku, S.M.; Babu, D.; Martin, E.M.; Koo, O.K.; O’Bryan, C.A.; Crandall, P.G.; Ricke, S.C. Cleaning and decontamination efficacy of wiping cloths and silver dihydrogen citrate on food contact surfaces. J. Appl. Microbiol. 2012, 113, 89–95. [Google Scholar] [CrossRef] [PubMed]
- Huang, R.; Dawson, C.O.; Hussain, M.A. Microbiological quality of selected meat products from the Canterbury Region of New Zealand. Int. J. Food Saf. 2014, 16, 12–16. [Google Scholar]
- Soliman, R.M.; Abdel Salam, R.A.; Eid, B.G.; Khayyat, A.; Neamatallah, T.; Mesbah, M.K.; Hadad, G.M. Stability study of thymoquinone, carvacrol and thymol using HPLC-UV and LC-ESI-MS. Acta Pharm. 2020, 70, 325–342. [Google Scholar] [CrossRef]
- Rutala, W.A.; Weber, D.J. Best practices for disinfection of noncritical environmental surfaces and equipment in health care facilities: A review. Am. J. Infect. Control 2019, 47, A96–A105. [Google Scholar] [CrossRef]
- Ristic, M.; Damme, K. Significance of pH-value for meat quality of broilers—Influence of breed lines. Vet. Glas. 2013, 67, 67–73. [Google Scholar] [CrossRef]
- Yu, L.H.; Lee, E.S.; Jeong, J.Y.; Paik, H.D.; Choi, J.H.; Kim, C.J. Effects of thawing temperatures on the physicochemical properties of pre-rigor frozen chicken breast and leg muscles. Meat Sci. 2005, 71, 375–382. [Google Scholar] [CrossRef]
- Lemos Junior, W.J.F.; Marques Costa, L.; Alberto Guerra, C.; Sales de Oliveira, V.; Gava Barreto, A.; Alves de Oliveira, F.; Paula, B.P.; Esmerino, E.A.; Corich, V.; Giacomini, A.; et al. Microbial landscape of cooked meat products: Evaluating quality and safety in vacuum-packaged sausages using culture-dependent and culture-independent methods over 1 year in a sustainable food chain. Front. Microbiol. 2024, 15, 1457819. [Google Scholar] [CrossRef]
- Milijasevic, J.B.; Milijasevic, M.; Djordjevic, V. Modified atmosphere packaging of fish—An impact on shelf life. IOP Conf. Ser. Earth Environ. Sci. 2019, 333, 012028. [Google Scholar] [CrossRef]
- Rodrigues, I.; Trindade, M.A.; Palu, A.F.; Baldin, J.C.; de Lima, C.G.; de Alvarenga Freire, M.T.A. Modified atmosphere packaging for lamb meat: Evaluation of gas composition in the extension of shelf life and consumer acceptance. J. Food Sci. Technol. 2018, 55, 3547–3555. [Google Scholar] [CrossRef] [PubMed]
- Gonzalez-Fandos, E.; Martinez-Laorden, A.; Perez-Arnedo, I. Combined effect of organic acids and modified atmosphere packaging on Listeria monocytogenes in chicken legs. Animals 2020, 10, 1818. [Google Scholar] [CrossRef] [PubMed]
- Rukchon, C.; Nopwinyuwong, A.; Trevanich, S.; Jinkarn, T.; Suppakul, P. Development of a food spoilage indicator for monitoring freshness of skinless chicken breast. Talanta 2014, 130, 547–554. [Google Scholar] [CrossRef]
- Byun, J.S.; Min, J.S.; Kim, I.S.; Kim, J.W.; Chung, M.S.; Lee, M. Comparison of indicators of microbial quality of meat during aerobic cold storage. J. Food Prot. 2003, 66, 1733–1737. [Google Scholar] [CrossRef] [PubMed]
- Talukder, S.; Mendiratta, S.K.; Biswas, A.K.; Sen, A.R.; Devadason, I.P.; Chand, S.; Ahmad, T.; Kumar, D.; Agrawal, R.K.; Tarafdar, A. Natural dye-based sensor for monitoring temperature variation in storage for chicken patties. Food Biosci. 2024, 60, 104425. [Google Scholar] [CrossRef]
- Burfoot, D.; Mulvey, E. Reducing microbial counts on chicken and turkey carcasses using lactic acid. Food Control 2011, 22, 1729–1735. [Google Scholar] [CrossRef]
- Soni, A.; Mendiratta, S.K.; Talukder, S.; Kumar, R.R.; Chand, S.; Jaiswal, R.K. Development of colorimetric on-package indicator for monitoring of chicken meat freshness during refrigerated storage (4 ± 1 °C). J. Anim. Res. 2018, 8, 847–853. [Google Scholar] [CrossRef]
- Jay, J.M.; Hollingshed, A.M. Two methods for determining extract release volume (ERV) of fresh and spoiled beef and poultry meats. J. Food Sci. 1990, 55, 1474–1475. [Google Scholar] [CrossRef]
- Miller, L.S. Relationships of Extract-Release Volume and Reduction of Resazurin and Tetrazolium Dyes to Microbial Contamination of Pork. Master’s Thesis, Michigan State University, East Lansing, MI, USA, 1968. [Google Scholar]
- Swami, J.N.; Raut, S.S.; Rindhe, S.N. Effect of freeze-thaw cycle on quality of rabbit meat. Haryana Vet. 2015, 54, 160–163. [Google Scholar]
- Jaiswal, R.K.; Mendiratta, S.K.; Talukdar, S.; Soni, A.; Bomminayuni, G.B. Comparative evaluation of dye reduction tests for assessment of microbial quality of chevon. Int. J. Livest. Res. 2018, 8, 133–139. [Google Scholar] [CrossRef]
- Selvan, P.; Mendiratta, S.K. Effect of chemical decontamination on quality of buffalo liver. Int. J. Curr. Microbiol. Appl. Sci. 2019, 8, 2729–2742. [Google Scholar]
- Necidová, L.; Zouharová, A.; Haruštiaková, D.; Bursová, Š.; Bartáková, K.; Golian, J. The effect of cold chain disruption on the microbiological profile of chilled chicken meat. Poult. Sci. 2024, 103, 104290. [Google Scholar] [CrossRef]
- González-Fandos, E.; Dominguez, J.L. Efficacy of lactic acid against Listeria monocytogenes attached to poultry skin during refrigerated storage. J. Appl. Microbiol. 2006, 101, 1331–1339. [Google Scholar] [CrossRef] [PubMed]
- Carrion, M.G.; Corripio, M.A.R.; Contreras, J.V.H.; Marrion, M.R.; Olan, G.M.; d Cazares, A.S.H. Optimization and characterization of taro starch, nisin, and sodium alginate-based biodegradable films: Antimicrobial effect in chicken meat. Poult. Sci. 2023, 102, 103100. [Google Scholar] [CrossRef] [PubMed]
- Lu, Y.; Wu, C. Reductions of Salmonella enterica on chicken breast by thymol, acetic acid, sodium dodecyl sulfate or hydrogen peroxide combinations as compared to chlorine wash. Int. J. Food Microbiol. 2012, 152, 31–34. [Google Scholar] [CrossRef] [PubMed]
- FSSAI. Food Safety and Standards (Food Products Standards and Food Additives) Tenth Amendment Regulations. Gazette of India Extraordinary 2016; Food Safety and Standard Authority of India: New Delhi, India, 2016. [Google Scholar]
- El Barbri, N.; Llobet, E.; El Bari, N.; Correig, X.; Bouchikhi, B. Electronic nose based on metal oxide semiconductor sensors as an alternative technique for the spoilage classification of red meat. Sensors 2008, 8, 142–156. [Google Scholar] [CrossRef]
- Chouliara, E.; Badeka, A.; Savvaidis, I.N.; Kontominas, M.G. Combined effect of irradiation and modified atmosphere packaging on shelf-life extension of chicken breast meat: Microbiological, chemical and sensory changes. Europ. Food Res. Technol. 2008, 226, 877–888. [Google Scholar] [CrossRef]
- Zhang, Q.Q.; Han, Y.Q.; Cao, J.; Xu, X.L.; Zhou, G.H.; Zhang, W.Y. The spoilage of air-packaged broiler meat during storage at normal and fluctuating storage temperatures. Poult. Sci. 2012, 91, 208–214. [Google Scholar] [CrossRef]
- Mol, S.; Erkan, N.; Ucok, D.; Tosun, S.Y. Effect of Psychrophilic bacteria to estimate fish quality. J. Muscle Foods 2007, 18, 120–128. [Google Scholar] [CrossRef]
- Ghollasi-Mood, F.; Mohsenzadeh, M.; Housaindokht, M.R.; Varidi, M. Microbial and chemical spoilage of chicken meat during storage at isothermal and fluctuation temperature under aerobic conditions. Iran. J. Vet. Sci. Technol. 2016, 8, 38–46. [Google Scholar]
- Raab, V.; Kreyenschmidt, J. Requirements for the effective implementation of innovative tools for temperature monitoring supporting cold chain management in poultry supply chains. In Proceedings of the 3rd International Workshop on Cold Chain Management, Bonn, Germany, 2–3 June 2008; pp. 259–264. [Google Scholar]
- Nychas, G.J.E.; Skandamis, P.N.C.; Tassou, C.; Koutsoumanis, K.P. Meat spoilage during distribution. Meat Sci. 2008, 78, 77–89. [Google Scholar] [CrossRef]
- Samelis, J.; Sofos, J.N. Yeasts in meat and meat products. In Yeasts in Food: Beneficial and Detrimental Aspects; Boekhout, T., Robert, V., Eds.; Behr’s Verlag GmbH: Hamburg, Germany, 2003; pp. 239–265. [Google Scholar]
- Tayel, A.A.; El-Tras, W.F.; Moussa, S.H.; El-Sabbagh, S.M. Surface decontamination and quality enhancement in mea steaks using plant extracts as natural biopreservatives. Foodborne Pathog. Dis. 2012, 9, 755–761. [Google Scholar] [CrossRef]
- Tura, M.; Gagliano, M.A.; Valli, E.; Petracci, M.; Gallina Toschi, T.A. Methodological review in sensory analyses of chicken meat. Poult. Sci. 2024, 103, 104083. [Google Scholar] [CrossRef] [PubMed]
- Talukder, S.; Mendiratta, S.K.; Kumar, R.R.; Agrawal, R.K.; Soni, A.; Luke, A.; Chand, S. Jamun fruit (Syzygium cumini) skin extract based indicator for monitoring chicken patties quality during storage. J. Food Sci. Technol. 2020, 57, 537–548. [Google Scholar] [CrossRef] [PubMed]
- Hinton, A., Jr. Formulating poultry processing sanitizers from alkaline salts of fatty acids. J. Food Microbiol. Saf. Hyg. 2017, 1, 116–117. [Google Scholar]
- Sujiwo, J.; Kim, D.; Jang, A. Relation among quality traits of chicken breast meat during cold storage: Correlations between freshness traits and torry-meter values. Poult. Sci. 2018, 97, 2887–2894. [Google Scholar] [CrossRef] [PubMed]
- Ayres, J.C.; Ogilvy, W.S.; Stewart, G.F. Post mortem changes in stored meats. I. Microorganisms associated with development of slime on eviscerated cut-up poultry. Food Technol. 1950, 4, 199–205. [Google Scholar]
- Irfan, I.; Lubis, Y.M.; Ryan, M.; Yunita, D.; Lahmer, R.A. Effect of halal-certified slaughterhouses and storage time on microbiology and organoleptic quality of broiler chicken meat. Indones. J. Halal Res. 2023, 5, 1–11. [Google Scholar] [CrossRef]
- Erkmen, O.; Faruk Bozoglu, T. Spoilage of Meat and Meat Products; John Wiley & Sons: New York, NY, USA, 2016; Volume 1, pp. 279–295. [Google Scholar]

| Sl. No. | Ingredients | C | F-1 (%) | F-2 (%) | F-3 (%) |
|---|---|---|---|---|---|
| 1. | Sterilized deionized water (SDW) | 85 | 78 | 73 | 68 |
| 2. | Plant extracts | 15 | 10 | 15 | 20 |
| 3. | Glacial acetic acids | - | 2 | 2 | 2 |
| 4. | Citric acid | - | 1 | 1 | 1 |
| 5. | Sodium chloride | - | 3 | 3 | 3 |
| 6. | Sodium bicarbonate | - | 2 | 2 | 2 |
| 7. | Sodium benzoate | - | 0.5 | 0.5 | 0.5 |
| 8. | Potassium sorbate | - | 0.2 | 0.2 | 0.2 |
| 9. | Lactic acid | - | 3 | 3 | 3 |
| 10. | Thyme essential oil (TEO) | - | 0.2 | 0.2 | 0.2 |
| 11. | Nisin | - | 0.1 | 0.1 | 0.1 |
| Total | 100 | 100 | 100 | 100 | |
| Storage Temperature | Intervals of Study | Storage Period | ||||||
|---|---|---|---|---|---|---|---|---|
| Day 1 | Day 2 | Day 3 | Day 4 | Day 5 | Day 6 | Until Spoilage | ||
| 4 ± 1 °C | 1 day regular interval | Physicochemical, microbiological, and sensory quality attributes | ||||||
| TPC (log CFU/cm2) | C1 | C2 | T | |||
|---|---|---|---|---|---|---|
| B | 5.53 A ± 0.11 | ![]() | 5.52 A ± 0.12 | ![]() | 5.48 A ± 0.14 | ![]() |
| A | 5.52 A ± 0.11 | ![]() | 3.24 B ± 0.25 | ![]() | 3.17 B ± 0.25 | ![]() |
| LR | 0.01 log | 2.28 log | 2.31 log | |||
| p-value | 0.87883 | 0.00007 | 0.00005 | |||
| CI | 95%, −0.17, 0.19 | 95%, 1.79, 2.76 | 95%, 1.85, 2.77 | |||
| Quality Attributes | Storage Period | F-Value | ||||||
|---|---|---|---|---|---|---|---|---|
| Day 1 | Day 2 | Day 3 | Day 4 | Day 5 | Day 6 | |||
| Physicochemical Parameters | ||||||||
| pH | B | 6.43 aA ± 0.03 | 6.40 aA ± 0.01 | 6.30 abA ± 0.07 | 6.03 bcA ± 0.08 | 5.86 cA ± 0.09 | 5.75 cA ± 0.12 | 13.45 |
| A | 6.20 aB ± 0.03 | 6.18 aB ± 0.03 | 6.14 aB ± 0.02 | 6.07 abA ± 0.06 | 6.00 abB ± 0.07 | 5.83 bA ± 0.08 | 5.378 | |
| Total Volatile Basic Nitrogen (mg/100 g) | B | 8.64 dA ± 0.19 | 10.44 cdA ± 0.86 | 13.78 bcA ± 1.70 | 17.51 abA ± 0.90 | 20.06 aA ± 0.88 | 20.33 aA ± 0.53 | 26.44 |
| A | 7.76 dB ± 0.19 | 9.61 dB ± 0.85 | 13.30 cA ± 1.06 | 17.06 bA ± 0.50 | 19.58 abA ± 0.66 | 20.04 aA ± 0.28 | 60.00 | |
| Extract Release Volume (mL) | B | 23.69 aA ± 0.69 | 22.51 aA ± 0.33 | 19.67 bA ± 0.15 | 17.62 cA ± 0.37 | 16.83 cA ± 0.32 | 15.94 cA ± 0.59 | 49.12 |
| A | 21.95 aB ± 0.73 | 21.16 aB ± 0.72 | 20.05 abB ± 0.23 | 18.49 bcA ± 0.26 | 17.22 cA ± 0.39 | 16.77 cA ± 0.47 | 17.08 | |
| Microbiological Parameters (log CFU/g) | ||||||||
| Total Plate Count (TPC) | B | 5.48 bA ± 0.13 | 5.51 bA ± 0.33 | 5.63 abA ± 0.28 | 5.91 abA ± 0.27 | 6.04 abA ± 0.11 | 6.74 aA ± 0.32 | 3.34 |
| A | 3.17 eB ± 0.25 | 3.69 deB ± 0.10 | 4.13 cdB ± 0.03 | 4.72 bcB ± 0.23 | 5.35 abB ± 0.26 | 6.08 aB ± 0.28 | 25.16 | |
| Psychrophilic Count | B | 5.17 bA ± 0.07 | 5.28 abA ± 0.25 | 5.63 abA ± 0.14 | 5.87 abA ± 0.26 | 6.02 abA ± 0.22 | 6.14 aA ± 0.25 | 3.37 |
| A | 3.48 cB ± 0.43 | 3.72 bcB ± 0.36 | 3.91 bcB ± 0.51 | 4.56 abcB ± 0.55 | 5.3 abB ± 0.15 | 6.03 aA ± 0.25 | 6.07 | |
| Pseudomonas Count | B | 3.56 cA ± 0.16 | 4.09 bcA ± 0.39 | 4.76 abcA ± 0.17 | 4.94 abA ± 0.15 | 5.45 aA ± 0.28 | 5.63 aA ± 0.15 | 7.49 |
| A | 2.81 eB ± 0.23 | 3.05 deB ± 0.33 | 3.81 cdB ± 0.14 | 4.17 bcB ± 0.22 | 4.94 abA ± 0.19 | 5.50 aA ± 0.20 | 20.86 | |
| Yeast and Mold Count (YMC) | B | 2.26 aA ± 0.67 | 2.40 aA ± 0.80 | 2.48 aA ± 1.19 | 2.59 aA ± 0.85 | 2.91 aA ± 1.59 | 3.08 aA ± 1.26 | 2.13 |
| A | 1.40 bB ± 0.67 | 1.70 abB ± 0.80 | 2.08 abA ± 0.95 | 2.30 abA ± 1.50 | 2.53 abA ± 0.54 | 2.97 aA ± 0.86 | 2.88 | |
| Sensory Evaluation | ||||||||
| Color | B | 4.77 aA ± 0.06 | 4.41 aA ± 0.12 | 3.68 bA ± 0.17 | 2.25 cA ± 0.09 | 0.91 dA ± 0.19 | 0.87 dA ± 0.12 | 160.90 |
| A | 4.84 aB ± 0.08 | 4.52 aB ± 0.20 | 3.70 bA ± 0.08 | 2.73 cB ± 0.09 | 2.16 cB ± 0.24 | 0.95 dB ± 0.16 | 85.50 | |
| Odor | B | 4.62 aA ± 0.15 | 4.25 abA ± 0.11 | 3.66 bA ± 0.35 | 2.62 cA ± 0.12 | 0.83 dA ± 0.10 | 0.66 dA ± 0.15 | 81.82 |
| A | 4.95 aB ± 0.04 | 4.29 abA ± 0.10 | 3.75 bA ± 0.28 | 2.70 cA ± 0.13 | 1.29 dB ± 0.16 | 0.87 dA ± 0.10 | 107.20 | |
| Texture | B | 4.58 aA ± 0.15 | 4.33 aA ± 0.16 | 3.66 bA ± 0.16 | 2.58 cA ± 0.20 | 0.62 dA ± 0.12 | 0.41 dA ± 0.05 | 145.20 |
| A | 4.84 aB ± 0.10 | 4.41 abA ± 0.15 | 3.75 bB ± 0.11 | 2.83 cB ± 0.27 | 1.08 dB ± 0.15 | 0.54 dA ± 0.10 | 119.20 | |
| Overall Acceptability | B | 4.66 aA ± 0.21 | 4.37 aA ± 0.15 | 3.66 bA ± 0.16 | 2.50 cA ± 0.18 | 0.83 dA ± 0.16 | 0.29 dA ± 0.04 | 127.70 |
| A | 4.83 aB ± 0.10 | 4.50 abB ± 0.18 | 4.08 bB ± 0.08 | 2.91 cB ± 0.15 | 1.1.6 dB ± 0.24 | 0.54 dB ± 0.15 | 122.50 | |
| Dilution of Inoculum | |||
|---|---|---|---|
| 10−3 | 10−4 | 10−5 | |
| E. coli (Log CFU/cm2) | |||
| Before | 6.09 A ± 0.00 | 6.32 A ± 0.01 | 6.88 A ± 0.02 |
| After | 5.02 B ± 0.01 | 5.26 B ± 0.04 | 5.74 B ± 0.04 |
| Log reduction | 1.06 ± 0.00 | 1.06 ± 0.03 | 1.14 ± 0.02 |
| p–value | 0.00000 | 0.00000 | 0.00000 |
| CI | 95%, 1.02, 1.10 | 95%, 0.94, 1.18 | 95%, 1.01, 1.25 |
![]() | |||
| S. aureus (Log CFU/cm2) | |||
| Before | 6.08 A ± 0.01 | 6.45 A ± 0.25 | 7.07 A ± 0.03 |
| After | 5.06 B ± 0.03 | 5.65 B ± 0.20 | 6.03 B ± 0.02 |
| Log reduction | 1.01 ± 0.02 | 0.80 ± 0.04 | 1.03 ± 0.00 |
| p-value | 0.00000 | 0.01451 | 0.00000 |
| CI | 95%, 0.93, 1.09 | 95%, 0.24, 1.36 | 95%, 0.90, 1.16 |
![]() | |||
Disclaimer/Publisher’s Note: The statements, opinions and data contained in all publications are solely those of the individual author(s) and contributor(s) and not of MDPI and/or the editor(s). MDPI and/or the editor(s) disclaim responsibility for any injury to people or property resulting from any ideas, methods, instructions or products referred to in the content. |
© 2025 by the authors. Licensee MDPI, Basel, Switzerland. This article is an open access article distributed under the terms and conditions of the Creative Commons Attribution (CC BY) license (https://creativecommons.org/licenses/by/4.0/).
Share and Cite
Talukder, S.; Sen, A.R.; Devadason, I.P.; Biswas, A.K.; Kumar, M.S.; Dhanze, H.; Bhilegaonkar, K.N.; Nguyen, H.; Grace, D.; Deka, R.P. Enhancing Chicken Meat Quality with User-Friendly Decontamination Wipes. Foods 2025, 14, 3391. https://doi.org/10.3390/foods14193391
Talukder S, Sen AR, Devadason IP, Biswas AK, Kumar MS, Dhanze H, Bhilegaonkar KN, Nguyen H, Grace D, Deka RP. Enhancing Chicken Meat Quality with User-Friendly Decontamination Wipes. Foods. 2025; 14(19):3391. https://doi.org/10.3390/foods14193391
Chicago/Turabian StyleTalukder, Suman, Arup Ratan Sen, Immanuel Prince Devadason, Ashim Kumar Biswas, Murthy Suman Kumar, Himani Dhanze, Kiran Narayan Bhilegaonkar, Hung Nguyen, Delia Grace, and Ram Pratim Deka. 2025. "Enhancing Chicken Meat Quality with User-Friendly Decontamination Wipes" Foods 14, no. 19: 3391. https://doi.org/10.3390/foods14193391
APA StyleTalukder, S., Sen, A. R., Devadason, I. P., Biswas, A. K., Kumar, M. S., Dhanze, H., Bhilegaonkar, K. N., Nguyen, H., Grace, D., & Deka, R. P. (2025). Enhancing Chicken Meat Quality with User-Friendly Decontamination Wipes. Foods, 14(19), 3391. https://doi.org/10.3390/foods14193391